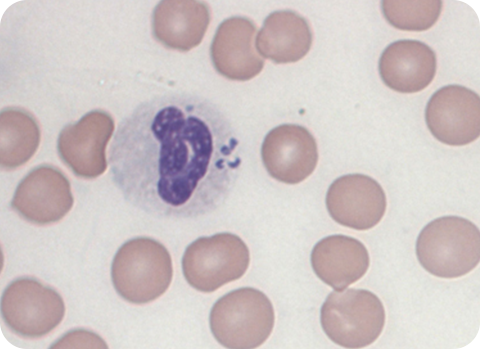
Anaplasmose wird durch die Zeckenart Gemeiner Holzbock übertragen und kann eine Störung der Blutgerinnung zur Folge haben.

ZECKEN BEIM HUND SIND GEFÄHRLICH
Zecken sind beim Hund wie beim Menschen gefährliche Krankheitsüberträger. Sie lauern im Wald, in Parks oder Gärten, auf Gräsern, Büschen oder Sträuchern und warten auf die nächste Blutmahlzeit. Gerade neugierige Hunde sind bei einem Aufenthalt im Freien gefundene Opfer für die berüchtigten Spinnentiere – und das zu jeder Jahreszeit. Zecken können Träger zahlreicher Viren oder Bakterien sein und ihr Stich (umgangssprachlich auch Zeckenbiss beim Hund) kann ernsthafte Infektionen auslösen. Sorge für den richtigen Zeckenschutz: FRONTLINE hilft als wirksames Mittel vorsorglich gegen Zecken beim Hund. Damit die Parasiten schnell unschädlich gemacht werden.
WANN SIND ZECKEN AKTIV?
Zecken lieben milde, sommerliche Temperaturen. Das heißt aber keineswegs, dass sie nur im Sommer aktiv sind. Die Zeckensaison geht in Deutschland von Februar bis in den späten Herbst. Genaugenommen genügt es bereits, wenn die Temperaturen an einigen aufeinanderfolgenden Tagen über 6°C liegen, denn dann erwachen Zeckenarten wie der Gemeine Holzbock aus ihrer Kältestarre und werden zur möglichen Gefahr für Hund und Halter. Milde Winter und ein wärmeres Klima sorgen inzwischen dafür, dass Zecken ganzjährig ein Thema sind.
Die Entwicklung der Zecken ist nicht mehr zwangsläufig von mehrmonatigen Ruhepausen durchbrochen, sie kann insgesamt schneller ablaufen. In jedem Entwicklungsstadium benötigen die Zecken Nahrung: ob als frisch geschlüpfte Larve, als mittelgroße Nymphe oder als ausgewachsener Parasit. Während Larven vor allem kleine Wirtstiere wie Mäuse bevorzugen, befallen Nymphen und adulte Zecken größere Wirte wie Hund, Katze oder Mensch.
AUF EINEN BLICK: INFOS ÜBER ZECKEN BEIM HUND
Was du biser noch nicht über Zecken wusstest:
- Zecken gehören nicht zu den Insekten, sondern sind Spinnen
- Umgangssprachlich heißt es auch "Zeckenbiss" beim Hund – die Parasiten stechen jedoch mit ihren Mundwerkzeugen und beißen nicht
- Zecken können mehrere Jahre ohne Nahrung auskommen
- Verbreitet durch Nagetiere und Vögel kommen Zecken auch in Gärten und Parks vor vor
- Eine der häufigsten Zeckenarten in Mitteleuropa heißt Gemeiner Holzbock
WIE GEFÄHRLICH SIND ZECKEN BEIM HUND?
Hat sich eine Zecke beim Hund festgesaugt, so nimmt sie sich für ihre Mahlzeit in der Regel mehrere Tage Zeit, bevor sie sich ablöst und fallen lässt. Während die Zecke im Fell leicht zu erkennen ist, ist ein Stich im Anschluss schwieriger zu identifizieren. Unter Umständen reagiert die Hundehaut mit Juckreiz und Schwellungen. Verstärktes Kratzen begünstigt sekundäre Entzündungen der Haut. So kann der Zeckenstich im Nachgang sogar Narbenbildung und Haarausfall auslösen.
Die größte Gefahr besteht aber darin, dass Zecken Krankheiten auf den Hund übertragen können. So verbreiten die Blutsauger unter anderem Fadenwürmer, Einzeller, Viren und vor allem Bakterien – teilweise mit verheerenden Folgen für ihre Opfer. Die Zeckenart Gemeiner Holzbock gilt daher als eines der gefährlichsten Tiere unserer Breiten.
WELCHE KRANKHEITEN ÜBERTRAGEN ZECKEN AUF HUNDE?
Zu den Krankheiten, die Zecken beim Hund auslösen können, gehören Anaplasmose, Ehrlichiose und Babesiose – Infektionen mit potentiell chronischem Verlauf. Früher galten Ehrlichiose und die schwerwiegendere, auch als Hundemalaria bezeichnete Babesiose noch als Reisekrankheiten, die zum Beispiel vom Urlaub aus dem Mittelmeerraum mitgebracht wurden – inzwischen breiten sich diese Erkrankungen jedoch zunehmend auch bei uns aus.
Dies hängt unter anderem mit der Verbreitung infizierter Zecken zusammen. Ehrlichiose wird in erster Linie von der Braunen Hundezecke übertragen, Babesiose von der Auwaldzecke – beides Zeckenarten, die ursprünglich in wärmeren Gefilden beheimatet waren und im Zuge veränderter klimatischer Bedingungen auch hierzulande auf dem Vormarsch sind. Mit der sogenannten Hyalomma-Zecke ist in den vergangenen Jahren sogar eine große tropische Zeckenart, die schwere infektiöse Fiebererkrankungen auslösen kann, nach Deutschland gelangt.
DIE HÄUFIGSTE ZECKENKRANKHEIT BEI HUNDEN: BORRELIOSE BEIM HUND
Die mit Abstand häufigsten Erreger sind Bakterien der Gattung Borrelia. Bei erfolgter Übertragung, z. B. durch den Gemeinen Holzbock, können sie die sogenannte Lyme-Borreliose auslösen – eine Krankheit, die zunächst mit leichten Symptomen wie Appetitlosigkeit oder Müdigkeit einhergeht, im weiteren Verlauf jedoch zu schweren Gelenk-, Herz- und Nervenschäden führen kann.
Borrelien sind bei Zecken in Deutschland weit verbreitet. In einigen Gebieten geht man sogar von bis zu dreißig Prozent infizierten Zecken aus. Anders als für Menschen oder auch für Katzen existiert für Hunde aber eine Schutzimpfung, die gegen die drei wichtigsten Arten von Borrelien hilft. Die Impfung verhindert, dass die Erreger aus den Zecken in den Hund gelangen und unterbindet somit eine Übertragung der Krankheit.
ZECKENSCHUTZ BEIM HUND: LIEBER VORSORGEN
FRONTLINE wirkt langanhaltend und kann bei Hunden vierwöchig vorbeugend als Spot-on oder Spray verwendet werden. Praktisch für Hundehalter*innen: FRONTLINE wirkt auch effektiv gegen Flöhe und Haarlinge beim Hund, FRONTLINE TRI-ACT sogar gegen Flöhe und fliegende Insekten. Einen effektiven Schutz gegen Zecken stellt beim Hund die Prophylaxe in Kombination mit einem Zeckenmittel dar. Daher empfiehlt es sich beispielsweise nach einem Spaziergang das Fell Ihres Lieblings abzusuchen. Achten Sie dabei besonders auf die Stellen, an welchen Zecken zuerst auf den Hund gelangen können, also z. B. Kopf und Brust. Denn während Zecken beim Menschen oft erst nach mehreren Stunden zustechen, tun sie dies bei Hunden meist direkt.
Neben Spot-ons und Sprays gibt es ganz auch Tabletten gegen Zecken beim Hund: FRONTPRO bietet als Kautablette einen wirksamen und effektiven Zeckenschutz für den Hund, und zwar gegen verschiedene Zeckenarten wie den Gemeinem Holzbock, die Auwaldzecke, die Braune Hundezecke oder die Igelzecke. FRONTPRO ist einfach zu verabreichen und wirkt bis zu einen Monat lang gegen Parasiten. Gleichzeitig kann FRONTPRO auch bei Hunden mit speziellen Diäten, besonderen Ernährungsbedürfnissen, Allergien und sogar dem MDR1-Gendefekt angewendet werden.
Hat sich bei deinem Hund tatsächlich eine Zecke festgesaugt, so ist die richtige Entfernung wichtig. Mit einem fachgerechten Werkzeug, z. B. einem Zeckenhaken, verhinderst du ein Quetschen der Zecke und verringerst das Infektionsrisiko. Auch sinkt die Wahrscheinlichkeit, dass die Mundwerkzeuge, oft als Kopf der Zecke bezeichnet, in der Wunde stecken bleiben. Verzichte außerdem auf die Verwendung sogenannter Hausmittel gegen Zecken beim Hund wie Alkohol, Kleber, oder Öl. Im Todeskampf der Zecke können durch sie vermehrt Erreger in die Stichwunde gelangen.
AUF EINEN BLICK: ZECKEN BEIM HUND RICHTIG ENTFERNEN
Wie du eine Zecke beim Hund richtig entfernst:
Verzichte auf vermeintlich wirksame Hausmittel gegen Zecken wie Öl, Kleber oder Alkohol - sie können mehr Schaden als Nutzen anrichten
- Fasse die Zecke mit einem geeigneten Werkzeug, z. B. einem Zeckenhaken, möglichst nah an der Haut
- Je nach Werkzeug, drehst oder ziehst du den Parasiten - so entfernst du die Zecke vom Hund
- Gehe behutsam vor und vermeide in jedem Fall ein Drücken oder Quetschen der Zecke
- Desinfiziere den Zeckenstich beim Hund, insbesondere wenn der sogenannte Kopf noch in der Wunde steckt
- Nach Entfernung der Zecke kannst du diesen z. B. mit Alkohol unschädlich machen
- Nutze vorbeugende Zeckenschutz-Präparate, beispielsweise FRONTLINE TRI-ACT für Hunde
- Wenn du zu Kautabletten tendierst, kannst du auch auf FRONTPRO gegen Zecken zurückgreifen
GEHEN ZECKEN VOM HUND AUF DEN MENSCHEN?
Auch für den Menschen stellen Zecken eine ernstzunehmende Bedrohung dar – Infektionen mit Borreliose oder auch der virusbedingten Frühsommer-Meningoenzephalitis (FSME) kommen immer wieder vor. Während sich gegen FSME in ausgewiesenen Risikogebieten eine Impfung empfiehlt, hilft gegen Borreliose vor allem Umsicht und Vorsorge. Nach Ausflügen ist besondere Vorsicht geboten – denn auch der Hund bringt hungrige Zecken mit in die Wohnung.
Eine spezielle Rolle nimmt hierbei die Braune Hundezecke ein – anders als zum Beispiel der Gemeine Holzbock, der in Innenräumen nur wenige Tage überlebt, kann sich diese Zeckenart in der Wohnung einnisten und vermehren. Binnen einiger Monate kann so eine regelrechte Plage entstehen, die auch zu einer Gefahr für den Menschen wird. In diesem Fall ist dringend professionelle Schädlingsbekämpfung vonnöten.
NEUES AUS DER WELT DER ZECKEN


Wie entferne ich Zecken beim Hund? Was, wenn der Kopf der Zecke noch in der Hundehaut steckt? Und wann zum Experten? Die wichtigsten Fragen zum Thema Zecke entfernen beim Hund.


Fieber, Abgeschlagenheit & Gelenkschwellungen können bei Hunden Symptome einer Borreliose sein, die vor allem durch die Zeckenart "Gemeiner Holzbock" übertragen wird.


Anaplasmose wird auf Hunde meist durch Zecken übertragen, Symptome können Abgeschlagenheit, Fieber oder auch Durchfall sein. Wie schützt man seinen Hund?


Babesiose ist eine als "Hundemalaria" bekannte und durch Zecken übertragbare Krankheit auf Hunde. Wie schütze ich meinen Vierbeiner effektiv?


Was ist Ehrlichiose bei Hunden und ist die Krankheit ansteckend oder heilbar? Mehr Infos hier.


Mittelmeerkrankheiten werden durch Mücken oder Zecken übertragen und begrenzen sich längst nicht mehr nur auf die Mittelmeerregion. Auch in Deutschland häufen sich Erfahrungsberichte.


Natürliche Zeckenmittel sind in aller Munde. Laut Experten sind jedoch deren vermeintlichen Wirkweisen & Risiken den meisten Tierhaltern unbekannt.


Tigermücke, Stechfliege & Co. - die fliegenden Angreifer aus der Luft haben es nicht nur auf uns Menschen, sondern auch auf unsere Vierbeiner abgesehen. Wie schütze ich meinen Hund effektiv?


Verhalten sich Hunde ungewöhnlich unruhig und kratzen sich häufig, kann ein Flohbefall das Problem sein. Wie wird man die Parasiten wieder los?


Eine der häufigsten Erkrankungen, ausgelöst durch einen Flohbefall ist die Flohspeichelallergie-Dermatitis (FAD). Juckreiz, Haarausfall und entzündliche Hautreaktionen sind meist die Folge.


Zoonosen können Pandemien auslösen, so die Pest im mittelalterlichen Europa oder die Infektionskrankheit COVID-19. Doch was sind Zoonosen eigentlich?


Haarlinge gehören zu den Läusen und können bei Hunden Unruhe, Nervosität und Juckreiz auslösen. Wie Sie Haarlinge behandeln und wieder loswerden können, erfahren Sie hier.


Ohrmilben, Nasenmilben, Pelzmilben - es gibt unterschiedliche Milbenarten, die bei einem Befall verschiedene Symptome hervorrufen können. Wie also Milben beim Hund erkennen und behandeln?


Herbstgrasmilben können bei Hund und Katze juckende Hautreizungen und Allergien auslösen. Doch wie erkenne ich einen Befall und was dann tun?


Der Kontakt von Hunden mit einem Eichenprozessionsspinner kann von Juckreiz über Fieber bis hin zum allergischen Schock reichen. Doch wie schütze ich meinen Vierbeiner?


Würmer kommen bei Hunden häufiger vor als den meisten Tierhaltern bewusst ist. Doch wie erkenne ich eigentlich einen Bandwurm bei Hunden?


Der Gemeiner Holzbock ist die häufigste Zeckenart Deutschlands. Doch wie erkennt und bekämpft man die Holzbock-Zecke?


Die Braune Hundezecke ist auf Hunde spezialisiert. Obwohl die Zeckenart in Deutschland weniger bekannt ist, zählt sie zu den häufigsten Zeckenarten weltweit.